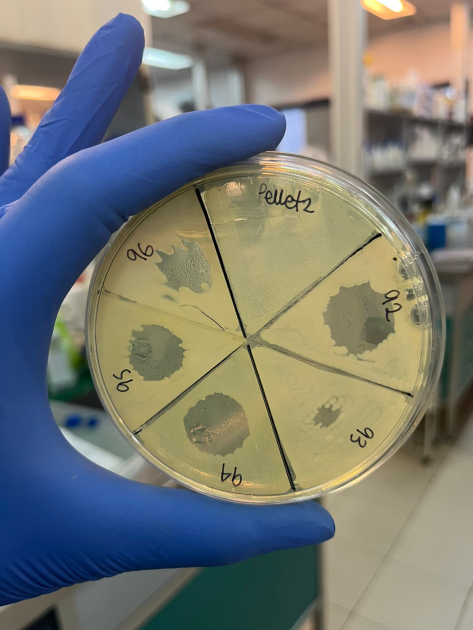
Sensibilidad al antibiótico colistina en aislamientos de enterobacterias del suelo Sensibilidad al antibiótico colistina en aislamientos de enterobacterias del suelo
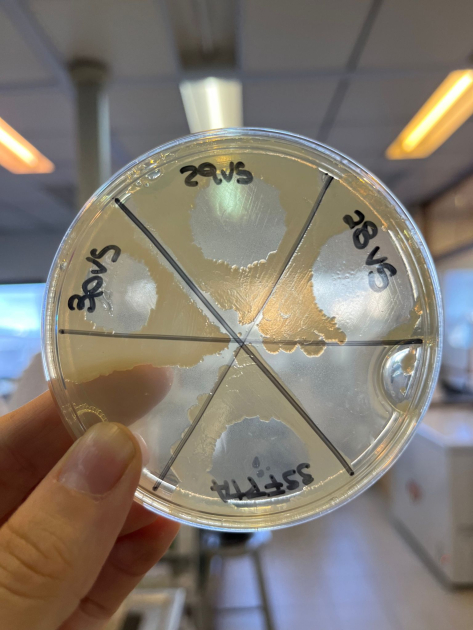
Sensibilidad al antibiótico colistina en aislamientos de enterobacterias del suelo Sensibilidad al antibiótico colistina en aislamientos de enterobacterias del suelo

Semana Mundial de Concientización sobre el Uso de los Antimicrobianos

Esta iniciativa, impulsada por la Organización Mundial de la Salud (OMS), busca sensibilizar a la población y profesionales sobre la importancia de un uso responsable de los antimicrobianos para intentar frenar el creciente aumento de la resistencia antimicrobiana (RAM).
La resistencia antimicrobiana ocurre cuando bacterias, virus, hongos o parásitos desarrollan mecanismos que reducen o anulan la eficacia de los tratamientos antimicrobianos, lo que convierte infecciones previamente tratables en amenazas mayores para la salud pública.
En el Instituto Clemente Estable valoramos esta semana como una ocasión para reflexionar y actuar en tres aspectos simultáneos: la educación, la investigación y la aplicación comunitaria.
Nos interesa que se sepa qué es la resistencia antimicrobiana y por qué es urgente: la propagación de infecciones multirresistentes incrementa la morbilidad, la mortalidad, los costos de atención en salud y debilita los sistemas sanitarios.
En lo que respecta a la investigación, en el Instituto contribuimos al conocimiento sobre la RAM mediante diversas líneas de trabajo que profundizan en la detección de bacterias resistentes en animales de producción —como bovinos y aves—, en bacterias asociadas a la clínica humana, así como bacterias presentes en el suelo y en el agua. También caracterizamos los mecanismos moleculares que permiten a las bacterias transferir la resistencia, lo que nos ayuda a determinar el mayor riesgo de propagación en ciertos microorganismos o sitios de estudio. Además, desarrollamos proyectos orientados a generar alternativas al uso de antibióticos, como el empleo de nanopartículas o el desarrollo de nuevas vacunas para tratar infecciones bacterianas, entre otros enfoques.
Durante esta Semana de Concientización sobre la RAM reforzamos nuestro llamado a la participación activa de la comunidad:
- Usar antimicrobianos solo cuando sea necesario y bajo prescripción profesional, evitando automedicación o uso innecesario.
- Seguir correctamente el tratamiento indicado (dosis, duración), y completar los ciclos aunque los síntomas desaparezcan. Interrumpir el tratamiento favorece la supervivencia de variantes resistentes.
- Informarse y apoyar la investigación, ya que el desarrollo de nuevos antimicrobianos, la vigilancia genómica y la prevención de infecciones son pasos clave para enfrentar la resistencia.
En el Instituto Clemente Estable reafirmamos nuestro compromiso con una ciencia responsable, ética y de impacto.
Desde el laboratorio y con la comunidad, trabajamos para que el conocimiento genere salud y bienestar.
Galería de imágenes
Sensibilidad al antibiótico colistina en aislamientos de enterobacterias del suelo Descargar imagen : Sensibilidad al antibiótico colistina en aislamientos de enterobacterias del suelo
Sensibilidad al antibiótico colistina en aislamientos de enterobacterias del suelo Descargar imagen : Sensibilidad al antibiótico colistina en aislamientos de enterobacterias del suelo
